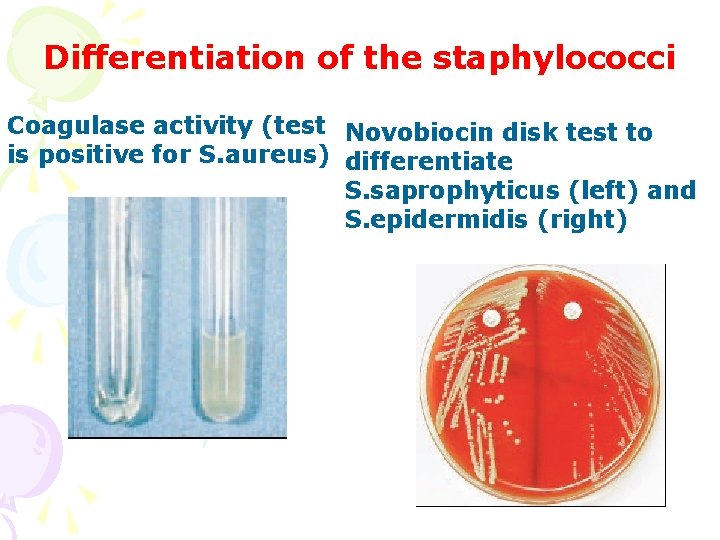
Differentiation of the staphylococci Coagulase activity (test Novobiocin disk test to is positive for
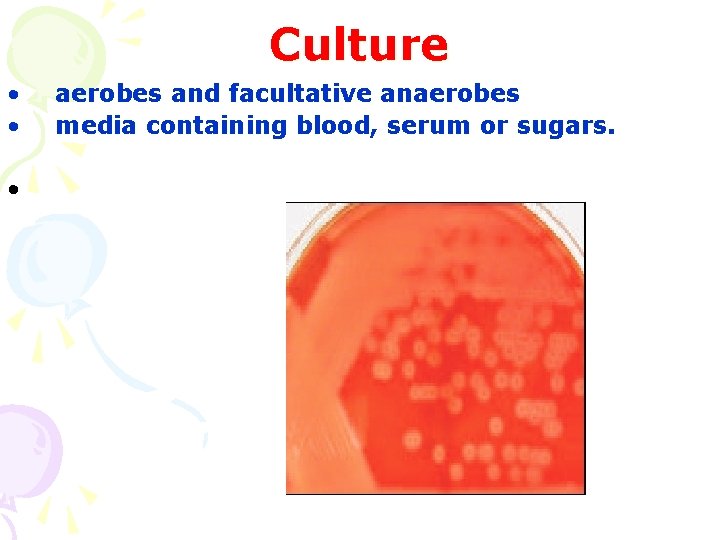
Culture • • • aerobes and facultative anaerobes media containing blood, serum or sugars.
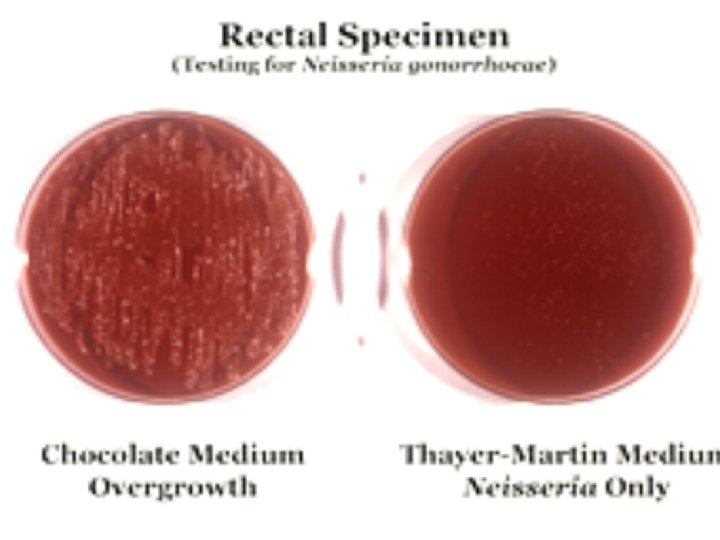

Pathogenic and opportunistic cocci Classification biological properties Staphylococci

Pathogenic and opportunistic cocci. Classification, biological properties. Staphylococci, streptococci, gonococci and meningococci.

Staphylococcus Classification • Family – Micrococcaceae • Genus – Staphylococcus • Species: 1. S. aureus 2. S. epidermidis 3. S. saprophyticus

Staphylococci in the pure culture and in the pus smears

Culture • They grow readily on ordinary culture media • The optimal temperature being 370 C and p. H 7, 4 -7, 6 • They are aerobes and facultative anaerobes • Culture media: nutrient agar, blood agar, salt media

Differentiation of the S. aureus from opportunists Hemolysis appearance on the blood agar DNAase activity (on the top)
Differentiation of the staphylococci Coagulase activity (test Novobiocin disk test to is positive for S. aureus) differentiate S. saprophyticus (left) and S. epidermidis (right)

Pathogenesis • Staphylococcal diseases may be classified as 1. Cutaneous infections 2. Deep infections 3. Food poisoning 4. Nosocomial infections (hospital infections) 5. Skin exfoliative disease (staphylococcal scalded skin syndrome) 6. Toxic shock syndrome

Laboratory diagnosis • Direct microscopy • Culture.

The characteristics help to distinguish the pathogenic strains from non-pathogenic strains • • Beta type of haemolysis on blood agar Production of a golden yellow pigment Coagulase production Mannitol fermentation Gelatin liquefaction Phosphatase production Production of enzyme deoxyribonuclease Tellurite reduction

Prophylaxis • General prophylaxis.

Staphylococcus aureus

Streptococcus Classifications: A. Due to type of hemolysis B. Lancefield´s classification (serological) C. Due to phylogenetic relationship

Different types of hemolysis Α -Hemolysis Β-Hemolysis Γ-Hemolysis

S. pyogenes (smears from the agar culture(on the left) and sugar broth (on the right)

S. pneumoniae (smears from the pure culture and from the sputum)
Culture • • • aerobes and facultative anaerobes media containing blood, serum or sugars.

Laboratory diagnosis • Suppurative infections : microscopy and pure culture isolation • Non-suppurative sequelae: serology

Streptococcus pyogenes

Neisseria • Classification • Family - Neisseriaceae • Genus – Neisseria • Species: 1. N. meningitidis 2. N. gonorrhoeae

N. meningitidis in the smears from the pure culture and clinical sample

Culture • They are strict aerobes. • The optimum temperature and p. H for growth are 35 -360 C and 7, 4 -7, 6 respectively. • Growth occurs in media enriched with blood, serum or ascitic fluid.

Antigenic classification • N. meningitidis has been divided into 13 serogroups

Laboratory diagnosis • • • Direct microscopy Antigen detection Culture. Serology Polymerase chain reaction.

Prophylaxis • Chemoprophylaxis • Immunoprophylaxis.

Neisseria meningitidis

N. gonorrhoeae

Laboratory diagnosis • Direct microscopy. • Culture. • Serology
- Slides: 28